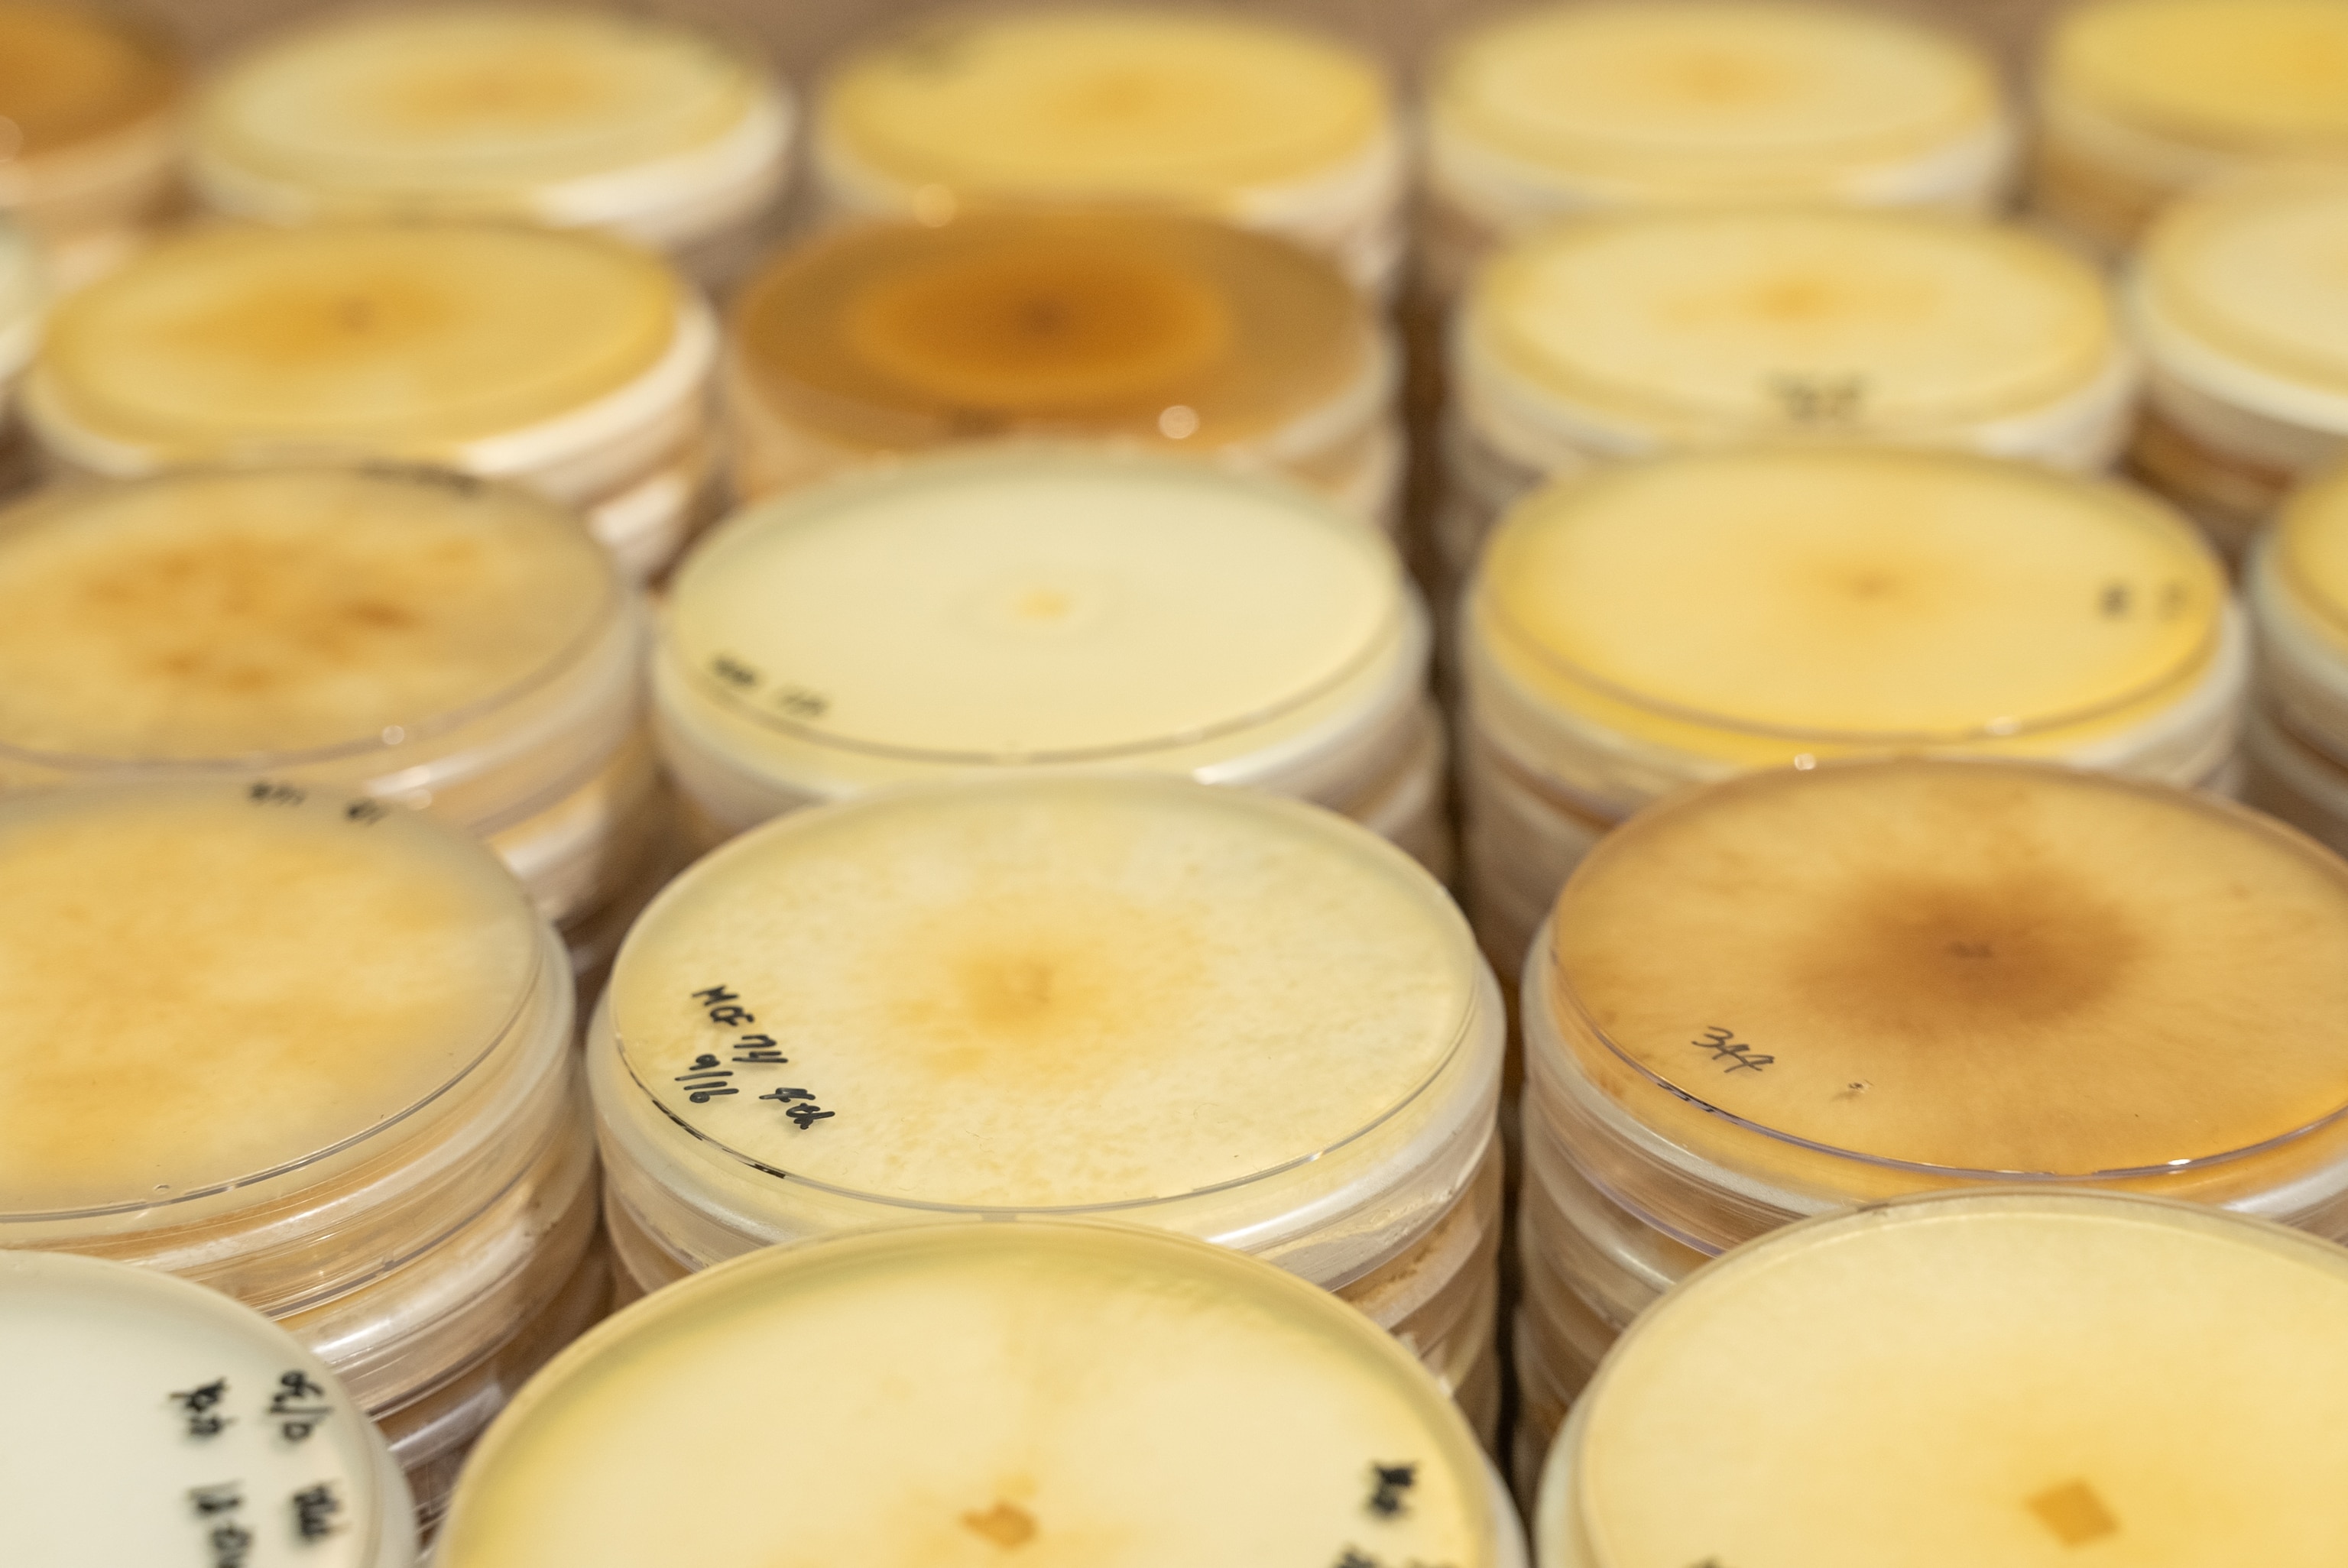
Image showing research on growth conditions of mycelium

Mushrooms inspire engineers to build a better future
Innovations in myco-technology are providing solutions for everything from construction to cars, fashion to furniture
Growing buildings from mushrooms may sound like something out of a science fiction novel, but scientists are turning the fantasy into reality.
Using the mycelium (root-like filaments) of various kinds of fungi—of which mushrooms are the fruiting bodies—scientists are growing bricks and other materials used in the construction industry.
Considering that fungi, the kingdom of organisms including rusts, molds, mildews and yeasts, are natural and abundant, and that the construction industry is responsible for just over 10 percent of the world’s carbon emissions, a significant portion of which comes from cement production, they offer hope for a far more environmentally friendly building solution.
It is not only the construction industry that is experimenting with mycelium. Innovators in everything from fashion to furniture production, and medical supplies to electronics, are being inspired by the circularity of nature, where waste is continually broken down to create something new in a closed-loop system.


Products made from fungal biotechnology include packaging, leather-replacement materials, and household objects.
“Mycelium is the holy grail,” says structural engineer and architect Arthur Huang. “As the by-product of the degradation of organic waste, it’s a step beyond using existing waste to make something new—it’s actively taking away what we don’t need while making new materials.”

Fungi, of which there are estimated to be 2–11 million species, although only around 150,000 have been formally named, are nature’s recyclers, breaking down organic matter. The branching threads of fungal mycelia, called hyphae, excrete substances that break down a food source before ingesting the nutrients. This means they can be used to eliminate contaminants that might otherwise not be biodegradable—a process called mycoremediation. They are able to break down long chains of hydrocarbons, including toxic and petroleum-based elements, such as plastics and unrefined oil.
As they digest the nutrients they require, they continue to grow, spreading their fiber-rich mycelia. These tendrils can be grown into bricks or other shapes, and processed in various ways to create different materials.
South Korean start-up Mycel makes mycelium-based materials that can replace animal leather and synthetic plastic in various products, including fashion accessories and furniture. The start-up is also developing mycoprotein-based meat substitutes, eco-friendly cosmetics using culture by-products, packaging materials and building panels combined with sawdust.


Car manufacturer Kia is embracing innovation with fungi and has partnered with Mycel to develop their leather replacement based on mycelium. This new soft material can mimic a variety of textures and can be dyed. It is resistant to tearing, and has a high tensile strength, both of which are key for car seats that take heavy usage.

Methods of growing mycelium, and how it is processed, vary according to the end material being produced. To grow structures such as bricks, one practice is to spread fungal spores on a pre-conditioned substrate, usually agricultural waste such as straw or rice husks, inside molds. The spores germinate and grow, eventually filling the space inside the mold, binding materials into a solid block.
The process can take as little as five days, depending on the variety of fungus and the growing conditions. The mycelium’s food source can lend particular attributes to the end product: stiffer mycelium material develops, for example, when food substances are hard for fungi to digest, such as potato peels or wood chips. Increasing temperatures can be used to speed up the growth rate, while the process can be arrested through sunlight or the application of heat.
As mycelium technology is relatively new, its potential is still being explored. Huang is material testing a range of applications in the laboratory.
“Buildings always need a range of mechanical or surfacing items, not just bricks, but also tiles, or joints to hold up glass, for example,” he says. “We’re testing various manufacturing methods, including extrusion and injection, to create different materials and products.”
The US Defense Advanced Research Projects Agency (DARPA) is also interested in the possibilities of mycelium. The agency is working with US mycelium-technology pioneers Ecovative and university partners to develop a solution for rebuilding areas after a natural disaster. Reconstruction efforts are often time-intensive and costly, as most materials need to be imported, so the program aims to develop a method for growing local materials on site that can self-repair.
They are also experimenting with maintaining mycelium’s bioactivity so that it could actively self-repair when damaged, essentially creating living buildings.

Scientists are also thinking of mycelium’s extra-terrestrial applications: in California’s Silicon Valley, NASA’s Ames Research Center is working on a myco-architecture project to develop technologies that could grow fungi-based habitats on other planets and moons.
While NASA may be looking far into the future, here today on planet Earth there is scope for using mycelium in a myriad of settings. The technology is cheap, biodegradable, and eco-friendly, and may help reframe consumption habits away from our dominant approach of take, make and throw away.
Inspired by nature, engineers and scientists are advancing sustainability by finding ways to take less from the environment, and give back more. This brings hope for building a more stable future.